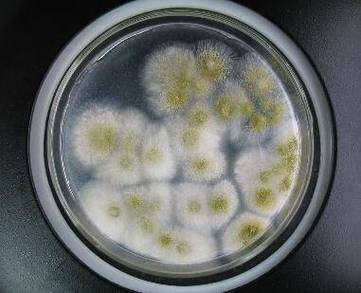

大家好,今天小编关注到一个比较有意思的话题,就是关于知名品牌菌落超48倍的问题,于是小编就整理了1个相关介绍知名品牌菌落超48倍的解答,让我们一起看看吧。
菌落计数器哪个牌子的好用,不容易坏?
青岛众瑞仪器的ZR-1100型全自动菌落计数仪, 好用 。 不需要调很多的参数就可以直接出结果,是非常理想的实验室装备,个人总结其最大优点在于 不需要调参数 用过其他几家的每次放上平皿后要进行调节直径啊 色度啊 圆度啊 哎每次一想到这些基本上就没兴趣开机使用了还不如自己数了,比较后、还是青岛众瑞的好用并且人家很大气、自信,可以让我们先试用 后付款而其价格合理包括培训才三万多块,前提是在厂家直接购买的哦。建议各位朋友要买的话一定记得要先使用后付款这样就不会被那些销售人员忽悠哦。 说点个人的经验:自动菌落计数仪呢,其实它主要就是个软件分析功能,就是把平皿先进行拍照,后用软件对图片进行分析,其实就是数出菌落的圆斑,这个就不要被销售人员忽悠了,买最贵的,其实成本上是一样的。
到此,以上就是小编对于知名品牌菌落超48倍的问题就介绍到这了,希望介绍关于知名品牌菌落超48倍的1点解答对大家有用。
